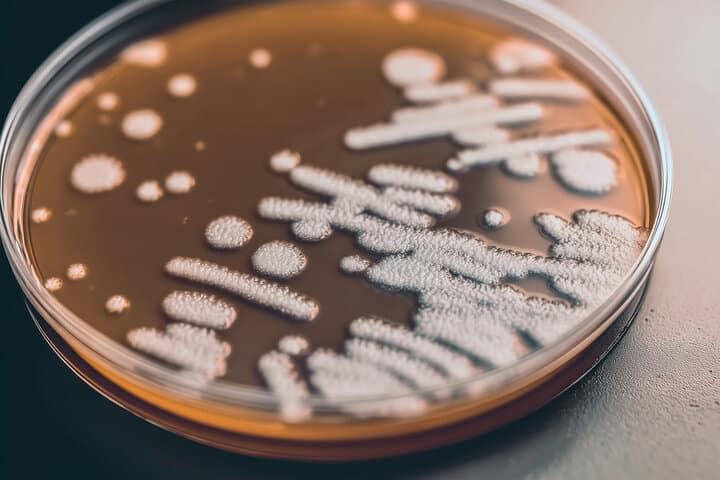

Wissenschaftler haben einen genetischen Mechanismus identifiziert, der neue Wege zur Behandlung einer seltenen, aber tödlichen Pilzinfektion aufzeigen könnte, die mehrere Intensivstationen von Krankenhäusern zur Schließung gezwungen hat. Die Entdeckung gibt Anlass zu Hoffnung im Kampf gegen einen Erreger, der schwer zu kontrollieren und nach seiner Ausbreitung fast unmöglich zu behandeln ist.
Eine globale Gesundheitsbedrohung mit mysteriösem Ursprung
Candida auris ist besonders gefährlich für Menschen, die bereits schwer krank sind, wodurch Krankenhäuser einem hohen Ausbruchsrisiko ausgesetzt sind. Obwohl der Pilz auf der Haut existieren kann, ohne Symptome zu verursachen, sind Patienten, die auf Beatmungsgeräte angewiesen sind, einem viel größeren Risiko ausgesetzt. Nach einer Infektion sterben etwa 45 Prozent der Patienten, und der Pilz ist gegen alle wichtigen Arten von Antimykotika resistent. Diese Resistenz macht die Behandlung extrem schwierig und ermöglicht es dem Erreger, sich in Krankenhäusern zu halten.
Die Infektion wurde erstmals 2008 entdeckt, ihr Ursprung ist jedoch nach wie vor unbekannt. Seitdem wurden Ausbrüche in mehr als 40 Ländern gemeldet, darunter auch Großbritannien. Candida auris, auch Candidozyma auris genannt, gilt mittlerweile als ernsthafte globale Gesundheitsbedrohung und steht auf der Liste der besonders gefährlichen Pilzpathogene der Weltgesundheitsorganisation. In Großbritannien ist die Zahl der gemeldeten Fälle stetig gestiegen.

Untersuchung der Infektion in einem lebenden Modell
Forscher der Universität Exeter haben nun einen wichtigen Schritt nach vorne gemacht, indem sie untersuchten, wie Gene während einer Infektion mit Candida auris aktiviert werden. Dies ist das erste Mal, dass eine solche genetische Aktivität in einem lebenden Wirt unter Verwendung eines auf Fischlarven basierenden Ansatzes untersucht wurde. Die Studie wurde in der Fachzeitschrift Communications Biology aus dem Nature-Portfolio veröffentlicht und von Wellcome, dem Medical Research Council (MRC) und dem National Center for Replacement, Reduction and Refinement (NC3Rs) unterstützt. Die Forscher sagen, dass die Ergebnisse dazu beitragen könnten, ein biologisches Ziel für neue antimykotische Behandlungen zu identifizieren oder sogar die Wiederverwendung bestehender Medikamente zu ermöglichen, wenn das gleiche genetische Verhalten während einer Infektion beim Menschen bestätigt wird.
Das Projekt wurde gemeinsam von Hugh Gifford, klinischer Dozent am NIHR und am MRC Center for Medical Mycology (CMM) der Universität Exeter, geleitet. Er sagte: „Seit seinem Auftreten hat Candida auris dort, wo es sich in Intensivstationen von Krankenhäusern festgesetzt hat, verheerende Schäden angerichtet. Es kann für gefährdete Patienten tödlich sein, und Gesundheitsbehörden haben Millionen für die schwierige Aufgabe der Ausrottung ausgegeben. Wir glauben, dass unsere Forschung eine Achillesferse dieses tödlichen Erregers während einer aktiven Infektion aufgedeckt hat, und wir brauchen dringend weitere Forschung, um zu untersuchen, ob wir Medikamente finden können, die diese Schwäche gezielt ausnutzen.“
Genetische Aktivität offenbart mögliche Schwachstellen
Eines der größten Hindernisse bei der Erforschung von Candida auris war seine Fähigkeit, hohe Temperaturen zu überstehen. In Verbindung mit seiner ungewöhnlich hohen Salztoleranz hat dies einige Forscher zu der Vermutung veranlasst, dass es seinen Ursprung in tropischen Ozeanen oder Meerestieren haben könnte. Diese Eigenschaften erschwerten auch die Untersuchung mit herkömmlichen Labormodellen. Um dieses Problem zu lösen, entwickelte das Team aus Exeter ein neues Infektionsmodell unter Verwendung von Arabischen Killifischen. Die Eier dieser Art können bei Temperaturen überleben, die denen des menschlichen Körpers ähneln, sodass sie sich gut für die Beobachtung von Infektionen unter Bedingungen eignen, die denen einer echten Erkrankung sehr nahe kommen.
Während der Experimente beobachteten die Forscher, dass Candida auris seine Form verändern kann, indem es längliche Pilzstrukturen bildet, die als Filamente bezeichnet werden. Diese Strukturen könnten dem Pilz dabei helfen, Nährstoffe zu suchen, während er einen Wirt infiziert. Das Team analysierte auch, welche Gene während der Infektion aktiviert oder ausgeschaltet wurden, um mögliche Schwachstellen zu identifizieren. Mehrere der Gene, die aktiv wurden, sind für die Produktion von Nährstoffpumpen verantwortlich, die eisenbindende Moleküle einfangen und Eisen in die Pilzzellen transportieren. Da Eisen für das Überleben unerlässlich ist, könnte dieser Prozess eine kritische Schwachstelle darstellen.

Mitautor Dr. Rhys Farrer vom MRC Centre for Medical Mycology der Universität Exeter sagte: „Bislang hatten wir keine Ahnung, welche Gene während der Infektion eines lebenden Wirts aktiv sind. Jetzt müssen wir herausfinden, ob dies auch bei Infektionen beim Menschen der Fall ist. Die Tatsache, dass wir Gene gefunden haben, die zur Eisenaufnahme aktiviert werden, gibt Hinweise darauf, wo Candida auris seinen Ursprung haben könnte, beispielsweise in einer eisenarmen Umgebung im Meer. Außerdem gibt es uns ein potenzielles Ziel für neue und bereits existierende Medikamente.“
Hoffnung für zukünftige Behandlungen
Dr. Gifford, der auch Facharzt für Intensivmedizin und Atemwegserkrankungen am Royal Devon & Exeter Hospital ist, betonte die klinische Bedeutung der Ergebnisse. Er sagte: „Obwohl noch eine Reihe von Forschungsschritten zu durchlaufen sind, könnte unsere Entdeckung eine vielversprechende Perspektive für zukünftige Behandlungen sein. Wir verfügen über Medikamente, die auf die Eisenverarmung abzielen. Wir müssen nun untersuchen, ob sie umfunktioniert werden können, um zu verhindern, dass Candida auris Menschen tötet und Intensivstationen in Krankenhäusern lahmlegt.“
Das Larvenmodell des Arabischen Killifisches wurde mit Unterstützung eines NC3Rs-Projektzuschusses als Alternative zu Maus- und Zebrafischmodellen entwickelt, die üblicherweise zur Untersuchung der Wechselwirkungen zwischen Krankheitserregern und ihren Wirten verwendet werden. Dr. Katie Bates, Leiterin der Forschungsförderung bei NC3Rs, sagte: „Diese neue Veröffentlichung zeigt die Nützlichkeit des Ersatzmodells für die Untersuchung von Candida-auris-Infektionen und liefert beispiellose Einblicke in zelluläre und molekulare Prozesse in lebenden infizierten Wirten. Dies ist ein brillantes Beispiel dafür, wie innovative alternative Ansätze die erheblichen Einschränkungen traditioneller Tierversuche überwinden können.“



